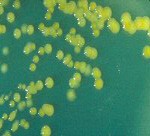
Enterobacter Sakazaki Siapa Takut?

Sudah sepekan berbagai media berisi isu tentang susu formula yang terkontaminasi bakteri ini. Tapi, sampai sekarang belum ada kejelasan dari pemerintah mengenai apa saja produk susu yang sekarang terkontaminasi oleh bakteri Enterobacter Sakazaki.
Walaupun begitu masyarakat, khususnya ibu-ibu yang mempunyai bayi berusia kurang dari satu tahun tidak perlu khawatir terhadap isu-isu yang beredar di berbagai media cetak dan elektronik tersebut. Memang, bakteri Enterobacter Sakazaki ini bersifat pathogen pada bayi.
SCROLL TO CONTINUE WITH CONTENT
Ada beberapa tips yang dapat bermanfaat bagi konsumen susu formula untuk menghindari produk susu yang sudah tidak layak untuk dikonsumsi.
Pertama, dalam membeli susu formula di pasaran, hendaknya dilihat tanggal kadaluarsanya. Hal ini penting untuk dilakukan karena dengan begitu kita dapat memberikan penilaian bahwa susu tersebut itu layak di konsumsi atau tidak.
Kedua, jangan lupa lihat kemasan susu tersebut.
Mudah-mudahan dengan uraian singkat tersebut, kita sebagai konsumen susu formula, khususnya ibu-ibu yang mempunyai bayi dibawah berusia 1 tahun, berhati-hati dalam memilih susu formula sebelum ada pengumuman resmi dari pemerintah mengenai produk susu yang terkontaminasi oleh enterobacter sakazaki.
Syafiq Hasan Futhuri
Mahasiswa Pendidikan Dokter FKIK UIN Syarif Hidayatullah Jakarta
shf_05@yahoo.co.id
085213977115
Foto:/ist.
(msh/msh)